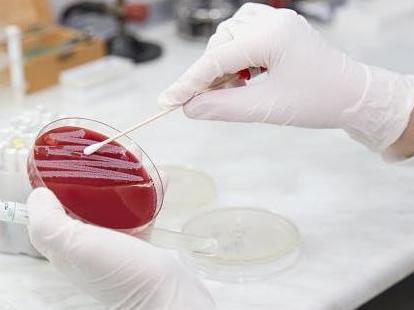
An urgent warning has been issued over the spread of antibiotic-resistant bacteria that has the potential to reach the UK

Urgent warning issued over spread of antibiotic-resistant bacteria that could reach UK
Antimicrobial resistant bacteria found to be spreading rapidly among severely malnourished children in Niger in ‘early warning’ to world
An urgent warning has been issued over the spread of antibiotic-resistant bacteria that has the potential to reach the UK.
Antimicrobial resistant bacteria is spreading rapidly among children being treated for severe malnutrition in a hospital facility in Niger, a new study has found.
The researchers described the concerning findings as an “early warning” to the world and a “stark reminder of how fast antimicrobial resistance can spread”, including to Britain.
Antibiotics are life-saving medicines that are becoming ineffective due to antimicrobial resistance (AMR) – a process in which bacteria, fungi and parasites have developed the ability to resist the action of medicines.
Professor Owen B Spiller, head of medical microbiology at Cardiff University and co-author of the new paper, told The Independent: “Due to increased international travel, antibiotic-resistant bacteria can and do reach the UK.

“What we’re seeing in Niger is a stark reminder of how fast antimicrobial resistance can spread when surveillance projects are under-resourced. AMR surveillance isn’t just about tracking bacteria locally, it’s a global early warning system. Without it, we’re flying blind as these superbugs evolve and cross borders.
“The UK government needs to sustain investment in monitoring resistance, not only to protect vulnerable populations in places like Niger, but to safeguard public health here in the UK.”
A UK government spokesperson said it recognises AMR as a “major threat” and is committed to urgently tackling its spread, with progress already made, including on reducing antibiotic use in meat.
Professor Spiller also said the new research on malnourished children “provides stark evidence that humanitarian crises amplify the silent pandemic of antimicrobial resistance”.
Globally, 45 million children under the age of five are estimated to be severely malnourished, according to the International Rescue Committee (IRC), with these children also at a higher risk of developing life-threatening infections like tuberculosis, or sepsis due to their weakened immune systems.
There is currently a worsening starvation crisis in Gaza. Medics there say dozens have died of malnutrition in recent days as hunger sets in, after Israel cut off all supplies to the enclave for nearly three months from March-May, and restricted supplies since.
Professor Spiller called on the international community to take action to prevent vulnerable children from dying from infections that should be easy to treat.
He said: “Without coordinated international action, combining antimicrobial stewardship, surveillance, and improved hygiene infrastructure, resistant bacteria will continue to spread unchecked. We urgently need global investment to safeguard antibiotics for children facing severe malnutrition in resource-limited settings.”
The new study, led by the Ineos Oxford Institute for antimicrobial research (IOI) with Médecins Sans Frontières (Doctors Without Borders), involved analysing over 3,000 rectal swabs from 1,371 children under the age of five being treated for severe malnutrition between 2016 and 2017.
Their findings, published in Nature Communications on Friday, showed that more than three-quarters (76 per cent) of children carried bacteria with extended-spectrum β-lactamase (ESBL) genes, which can break down many commonly used antibiotics.
One in four children carried bacteria with carbapenemase genes like blaNDM, which can cause resistance to some of the most powerful and last-resort antibiotics called carbapenems. More than two-thirds (69 per cent) of children who did not carry bacteria that was resistant to this strong class of antibiotics upon admission were found to carry them when they were discharged.
If antibiotic-resistant bacteria remain in the gut, these children could be at risk in the future of developing infections such as pneumonia, sepsis, diarrhoea and urinary tract infections that do not respond to antibiotic treatment, warned the researchers.
Dr Kirsty Sands, scientific lead at IOI and lead author, said: “These are some of the most vulnerable children in the world, and we’re seeing them pick up bacteria that don’t respond to life-saving antibiotics.
“While our study was focused in one treatment facility in Niger, this situation is likely mirrored in many more hospitals around the world. As AMR continues to increase globally, concurrent humanitarian crises such as wars and climate change are exacerbating malnutrition, leading to overcrowded treatment centres.”
Dr Céline Langendorf, a lab coordinator at MSF, added: “Our latest findings highlight the urgent need to prioritise infection prevention and control measures in hospitals to protect the most vulnerable patients. In crowded hospitals with limited resources, these bacteria can spread easily from child to child. Without urgent action, more children could die from infections that used to be easy to treat.”
A UK government spokesperson said: “Our 10 Year Health Plan recognises antimicrobial resistance (AMR) as a major threat and commits to urgently tackle its spread, including through new vaccines.
"We have made important progress – reducing antibiotic use in meat and pioneering a world-first subscription model to incentivise the development of new treatments. We also continue to work closely with international partners to influence global efforts to limit the spread of AMR.”
They said the government’s 2024-29 UK AMR National Action Plan includes commitments to strengthen surveillance to improve the UK’s capabilities to measure, predict, and mitigate the evolution and transmission of drug-resistant infections, locally, nationally and internationally.
They added that the government has galvanised global support at the UN, including the agreement of a political declaration on AMR, which included targets to reduce AMR deaths by 10 per cent by 2030.
Join our commenting forum
Join thought-provoking conversations, follow other Independent readers and see their replies
Comments
Bookmark popover
Removed from bookmarks